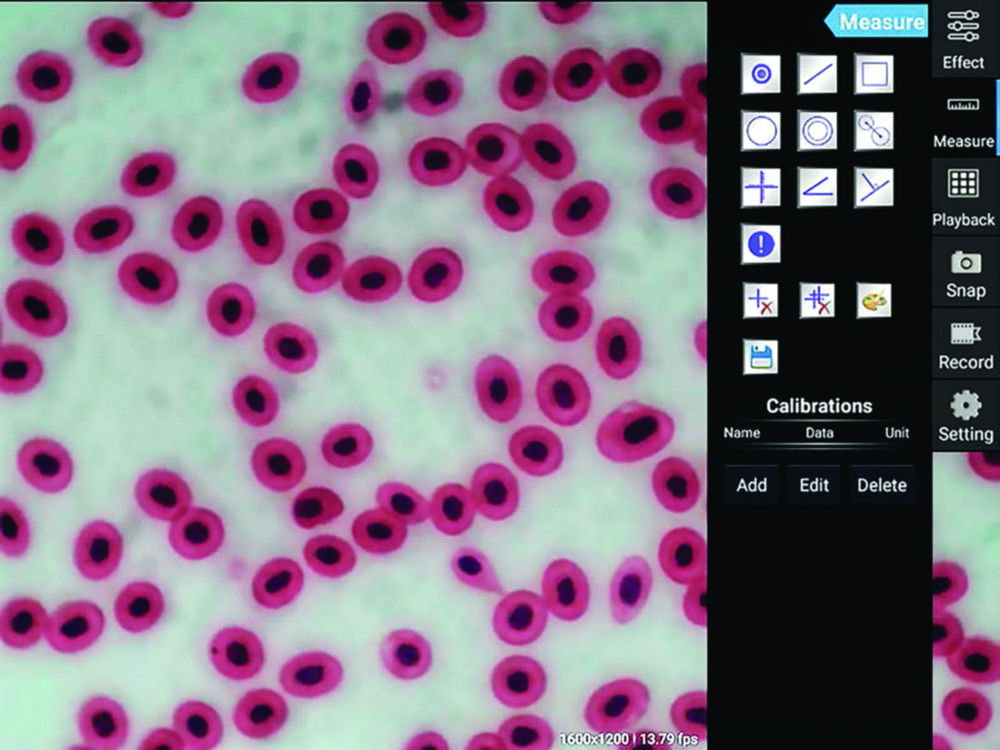
Tablet Kamera ODC

Produkte filtern
–
- Allgemeiner Laborbedarf
- Arbeitsschutz, Sicherheitstechnik
- Analytisches Messen und Testen
- Rühren, Schütteln, Mischen
- Probenvorbereitung
- Destillieren, Trennen, Filtrieren
- Kälte- und Wärmetechnik
- Liquid Handling
- Vakuumtechnik, Trocknung, Trockenlagerung
- Optische Instrumente und Mikroskope
- Reinigung und Sterilisation
- Umwelt-, Boden-, Wasser-, Lebensmittelanalytik
- Life Science
- Chromatographie
- Reinraum
- About Us
Greenough-Stereomikroskope Lab-Line OZL
Der flexible Allrounder mit Zoomfunktion für Schulen, Ausbildungswerkstätten, Prüfstellen und Labore.Tubus 45° geneigtWeitfeld Okulare HWF 10x/20 mmDioptirenausgleich beidseitigBeleuchtung: 3 W-LED Auflicht und 3 W-LED Durchlicht separat dimmbarAugenabstand 55 bis 75 mmVorsatzobjektive und weitere Okulare auf Nachfrage erhältlichOZL 466 mit starker, stufenlos dimmbarer, integrierter LED-Ringbeleuchtung im ObjektivgehäuseOZL 468 mit integriertem Griff und standfestem, mechanischen StänderMit Staubschutzhaube, Augenmuscheln und Bedienungsanleitung
Stereo-Zoom-Mikroskop OZP-5
Stereo-Zoom-Mikroskop mit überdurchschnittlichem Vergrößerungsbereich und robuster, ergonomischer Form.Optisches System: Greenough-OptikDioptrienausgleich beidseitigGroßen ArbeitsabstandGroßes SehfeldSäulenständerBeleuchtung 3 W LED (Durchlicht), 3 W LED (Auflicht)Beleuchtung unabhängig voneinander dimmbarLieferumfang:Stereo-Zoom-Mikroskop, Staubschutzhaube, Augenmuscheln, Betriebsanleitung
Tablet-Kamera Moticam 1080N BMH
Für die einfache Bedienung und die Anzeige von Live Bildern in Full HD (1920 x 1080 Pixel). Dank der On-Board-Software, können Messungen und Bildanpassungen vorgenommen werden. Die Daten können mit der Software Motic Image Plus 3.1 auf dem PC verarbeitet oder ohne Computer direkt auf einer SD-Karte gespeichert werden.LCD-BildschirmMicro-SD-KartensteckplatzUSB-AnschlussHDMI AnschlussLieferumfang: Kamera, CS-Ring-Adapter, 4-Punkt-Kalibrierungsschieber, Universalnetzteil, HDMI-Kabel, USB-Kabel, Software Motic Images Plus 3.1, Transportkoffer
Greenough-Stereomikroskop Educational-Line OSE
Ideal für Werkstätten, Schulen und Ausbildung.Tubus 45° geneigtWF 10×/ Ø 20 mmDioptrienausgleich beidseitigBeleuchtung 1 W-LED Auflicht und DurchsichtIntegrierter Griff und mechanischer Ständer
Schülermikroskope RED 211
Für den Einsatz an Schulen, Universitäten und in Laboren.Je nach Modell 1 oder 2 Weitfeld Okulare WF10X/18 mm4-fach Objektiv-Revolver, rückwärts gerichtetAchromatische Semi-Plan-Objektive SP 4X, 10X, 40XKoaxialer Grob- und FeintriebEingebauter Kreuztisch mit koaxialem TriebMonokulartubus 30°, 360° drehbarN.A. 1.25 Abbe Kondensor mit Irisblende3 W LED-Beleuchtung, regelbarLieferumfang:Mikroskop, Staubschutzhülle
Schülermikroskope RED 220
Für den Einsatz an Schulen, Universitäten und in Laboren.Je nach Modell 1 oder 2 Weitfeld Okulare WF10X/18 mm4-fach Objektiv-Revolver, rückwärts gerichtetAchromatische Semi-Plan-Objektive SP 4X, 10X, 40XKoaxialer Grob- und FeintriebEingebauter Kreuztisch mit koaxialem TriebBinokulartubus 30°, Siedentopf-Typ, 360° drehbarN.A. 1.25 Abbe Kondensor mit IrisblendeDioptrinausgleich am linken Tubus3 W LED-Beleuchtung, regelbarLieferumfang:Mikroskop, Staubschutzhülle
Schülermikroskope RED 223
Für den Einsatz an Schulen, Universitäten und in Laboren.Je nach Modell 1 oder 2 Weitfeld Okulare WF10X/18 mm4-fach Objektiv-Revolver, rückwärts gerichtetAchromatische Semi-Plan-Objektive SP 4X, 10X, 40XKoaxialer Grob- und FeintriebEingebauter Kreuztisch mit koaxialem TriebTrinokulartubus 30°, Siedentopf-Typ, 360° drehbarN.A. 1.25 Abbe Kondensor mit IrisblendeDioptrinausgleich am linken Okularstutzen3 W LED-Beleuchtung, regelbarLieferumfang:Mikroskop, Staubschutzhülle, 0,5x C-Mount Adapter
Schülermikroskope RED 230
Für den Einsatz an Schulen, Universitäten und in Laboren.Je nach Modell 1 oder 2 Weitfeld Okulare WF10X/18 mm4-fach Objektiv-Revolver, rückwärts gerichtetAchromatische Semi-Plan-Objektive SP 4X, 10X, 40XKoaxialer Grob- und FeintriebEingebauter Kreuztisch mit koaxialem TriebBinokulartubus 30°, Siedentopf-Typ, 360° drehbarFokussierbarer und zentrierbarer N.A. 1.25 Abbe Kondensor mit IrisblendeDioptrinausgleich am linken OkularstutzenKöhler 3 W LED-Beleuchtung, regelbarLieferumfang:Mikroskop, Staubschutzhülle
Schülermikroskope RED 233
Für den Einsatz an Schulen, Universitäten und in Laboren.Je nach Modell 1 oder 2 Weitfeld Okulare WF10X/18 mm4-fach Objektiv-Revolver, rückwärts gerichtetAchromatische Semi-Plan-Objektive SP 4X, 10X, 40XKoaxialer Grob- und FeintriebEingebauter Kreuztisch mit koaxialem TriebTrinokulartubus 30°, Siedentopf-Typ, 360° drehbarFokussierbarer und zentrierbarer N.A. 1.25 Abbe Kondensor mit IrisblendeDioptrinausgleich am linken OkularstutzenKöhler 3 W LED-Beleuchtung, regelbarLieferumfang:Mikroskop, Staubschutzhülle, 0,5x C-Mount Adapter
Stereomikroskope ohne Beleuchtung Serie SMZ-160
Universell einsetzbares und langlebiges Zoom-Stereomikroskop für den Einsatz in Lehreinrichtungen geeignet. Gleichzeitig werden die Anforderungen an Präzision und Qualitätskontrolle von Industrie, Forschung und Medizin erfüllt. Vielseitiges Zubehör erhältlich.Greenough-OptiksystemTubus 360º drehbarDioptrieneinstellung an beiden OkularenZoomverhältnis 6:1Grobfokussiersystem mit SpannungseinstellungMit Stativ für AuflichtbeleuchtungLieferumfang: Stereomikroskop, Tischeinsatz schwarz/weiß, StaubschutzhülleLichtquelle bitte separat bestellen
Stereomikroskope mit Beleuchtung Serie SMZ-160
Universell einsetzbares und langlebiges Zoom-Stereomikroskop für den Einsatz in Lehreinrichtungen geeignet. Gleichzeitig werden die Anforderungen an Präzision und Qualitätskontrolle von Industrie, Forschung und Medizin erfüllt. Vielseitiges Zubehör erhältlich.Greenough-OptiksystemTubus 360º drehbarDioptrieneinstellung an beiden OkularenZoomverhältnis 6:1Grobfokussiersystem mit SpannungseinstellungStativ mit Auf- und Durchlicht-BeleuchtungLED-Beleuchtung (3 W) mit IntensitätsregelungLieferumfang: Stereomikroskop, Tischeinsätze schwarz/weiß und Mattglas, Staubschutzhülle
Kamera-Adapter C-mount für Stereomikroskope Serie SMZ-160
Adapter zur Befestigung einer Mikroskopkamera an trinokulare Stereomikroskope.
Digitalmikroskop-Set OZL, mit C-Mount-Kamera
Das Set ist die digitale Komplettlösung, mit Zoomfunktion, für Schulen, Ausbildungswerkstätten, Prüfstellen und Labore.Optisches System: Greenough-OptikDioptrienausgleich beidseitigStänder (464, 466): SäuleStander (468): mechanischBeleuchtung: 3W LED (Durchlicht), 3W LED (Auflicht)Lieferumfang:Stereo-Zoom-Mikroskop, Kamera, C-Mount Adapter, Staubschutzhaube, Augenmuscheln, Betriebsanleitung
Digitalmikroskop-Set OZL, mit Tablet-Kamera
Das Set ist die digitale Komplettlösung, mit Zoomfunktion, für Schulen, Ausbildungswerkstätten, Prüfstellen und Labore.Optisches System: Greenough-OptikDioptrienausgleich beidseitigStänder (464, 466): SäuleStander (468): mechanischBeleuchtung: 3W LED (Durchlicht), 3W LED (Auflicht)Lieferumfang:Stereo-Zoom-Mikroskop, Kamera, Staubschutzhaube, Augenmuscheln, Betriebsanleitung
Stereo-Zoom-Mikroskop OZL-47
Die starke und stufenlos dimmbare LED-Doppel-Schwanenhalsbeleuchtung (Auflicht) sorgt für eine individuell und schnell verstellbare Ausleuchtung.Optisches System: Greenough-OptikDioptrienausgleich beidseitigGroße ArbeitsflächeSäulenständerBeleuchtung: 3 W LED (Auflicht)Lieferumfang:Stereo-Zoom-Mikroskop, Staubschutzhaube, Augenmuscheln, Betriebsanleitung
Stereo-Zoom-Mikroskop-Set OZP, mit C-Mount Kamera
Stereo-Zoom-Mikroskop mit überdurchschnittlichem Vergrößerungsbereich und robuster, ergonomischer Form.Optisches System: Greenough-OptikDioptrienausgleich beidseitigGroßen ArbeitsabstandGroßes SehfeldSäulenständerBeleuchtung 3 W LED (Durchlicht), 3 W LED (Auflicht)Beleuchtung unabhängig voneinander dimmbarLieferumfang:Stereo-Zoom-Mikroskop, Kamera, C-Mount Adapter, Staubschutzhaube, Augenmuscheln, Betriebsanleitung
Schüler-Stereomikroskope ST30C
Zur Beobachtung von kleinen, nicht speziell präparierten Objekten.Rückwärts gerichteter binokularer Tubus mit 45° EinblickwinkelDioptrienausgleich an linkem TubusstutzenWeitfeld-Okulare 10X/20 mmObjektivwechsler 2X/4X, achromatische Objektive, parfokal und parzentrischWolframbeleuchtung (12 V/ 10 W)Ledbeleuchtung (3,1 V/ 60 mW, Akkus, 50 h Laufzeit)Fokus mit robustem Zahnstangen-Mechanismus mit RutschkupplungMit 2 Tischeinsätzen (Ø 80 mm) aus Mattglas und aus Kunststoff (schwarz/weiß), mit Präparate-KlemmenSäulenstativ mit Auf-/Durchlicht
Stereomikroskope mit Beleuchtung Serie SMZ-171
Vielseitig einsetzbar für ein breites Spektrum biologischer und materialkundlicher Anwendungen. Mit überzeugenden optischen Eigenschaften, kompakter Bauweise und robuster Mechanik. Optional umfangreiches Zubehör erhältlich.Greenough-OptiksystemAuch in ESD-AusführungTubus 360° drehbarDioptrieneinstellung an beiden OkularenZoomfaktor 6,7:1Vergrößerung mit Vorsatzsystem von 2,3X bis 100X optionalGrobfokussiersystem mit SpannungseinstellungStativ mit Auf- und Durchlicht-BeleuchtungLED-Beleuchtung (3 W) mit IntensitätsregelungLieferumfang: Stereomikroskop, Tischeinsätze schwarz/weiß und Mattglas, Staubschutzhülle
Stereomikroskope ohne Beleuchtung Serie SMZ-171
Vielseitig einsetzbar für ein breites Spektrum biologischer und materialkundlicher Anwendungen. Mit überzeugenden optischen Eigenschaften, kompakter Bauweise und robuster Mechanik. Optional umfangreiches Zubehör erhältlich.Greenough-OptiksystemAuch in ESD-AusführungTubus 360° drehbarDioptrieneinstellung an beiden OkularenZoomfaktor 6,7:1Vergrößerung mit Vorsatzsystem von 2,3X bis 100X optionalGrobfokussiersystem mit SpannungseinstellungMit Stativ für AuflichtbeleuchtungLieferumfang: Stereomikroskop, Tischeinsatz schwarz/weiß, StaubschutzhülleLichtquelle bitte separat bestellen
Tablet Kamera ODC
Die Mikroskop-Tablet-Kamera besteht aus einem großen Android Tablet in Kombination mit einer 5-MP-Kamera, für alle trinokularen Mikroskope mit C-Mount- Adapter.9,7" LCD-TouchscreenInkl. Strecken-, Flächen- und Winkelmessungen, sowie manuelle ZählfunktionenAutomatischer Weißabgleich und KontrastausgleichLieferumfang: Tablet-Kamera mit vorinstallierter Software, Netzteil
Stereo-Zoom-Mikroskop-Set OZP, mit Tablet Kamera
Stereo-Zoom-Mikroskop mit überdurchschnittlichem Vergrößerungsbereich und robuster, ergonomischer Form.Optisches System: Greenough-OptikDioptrienausgleich beidseitigGroßen ArbeitsabstandGroßes SehfeldSäulenständerBeleuchtung 3 W LED (Durchlicht), 3 W LED (Auflicht)Beleuchtung unabhängig voneinander dimmbarLieferumfang:Stereo-Zoom-Mikroskop, Kamera, Staubschutzhaube, Augenmuscheln, Betriebsanleitung
Stereo-Mikroskop-Set OZL 963
Stereo-Mikroskop-Set mit einfachem Teleskoparm und Ringbeleuchtung.Optisches System: Greenough-OptikDioptrienausgleich beidseitigBeleuchtung 4,5 W LED (Auflicht), dimmbarLieferumfang:Stereomikroskopkopf, Universalständer, Halter, Ringbeleuchtung, Staubschutzhaube
Stereomikroskop, ST-36C
Binokulartubus, 45º Einblickwinkel, 360º drehbarWeitfeld Okulare WF10X/20mmObjektiv-Wechsler Typ C: 2X, 4XEinstellbarer GrobtriebEinfaches SäulenstativLED Auf- und Durchlichtbeleuchtung , wiederaufladbar (ST36C-6LED)Wolfram Auf- und Durchlichtbeleuchtung 12V/10W (ST36C-2L00)Netzteil 100-240V, VDE-Stecker (CE), inkl. Ladegerät und Batterien (ST36-C6LED)Netzteil 220-240V, VDE-Stecker (CE) (ST36C-2L00)Tischeinsätze schwarz, weiß und mattglas Ø 80 mm, Staubschutzhülle